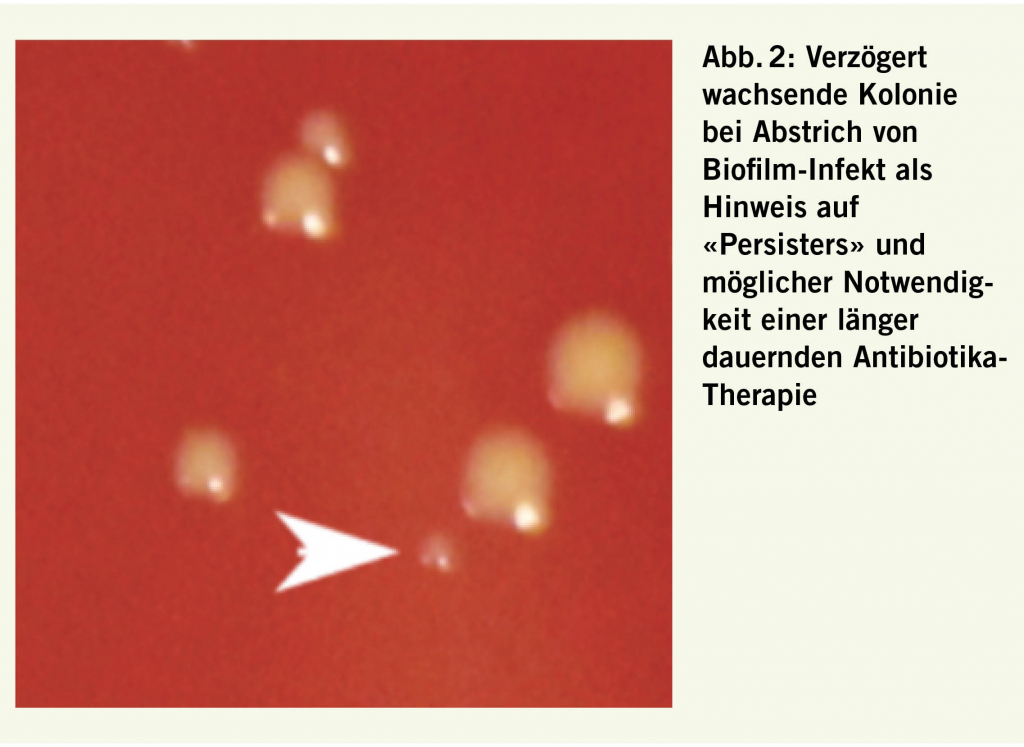

- Symposium der Vereinigung Zürcher Internisten 2019
Das VZI-Symposium 2019 ist seinem Ruf als hervorragende Fortbildungsveranstaltung für Internisten aller Couleur einmal mehr gerecht geworden. Unter der wissenschaftlichen (und praktischen) Organisation von Dr. med. Barbara Himmelmann und Prof. Stefan Vavricka wurde ein breit gefächertes hochstehendes Programm präsentiert, das stets in einem engen Bezug zur täglichen Praxis stand, Neues vermittelte und Bewährtes vertiefte.
Die Nachmittagssitzung wird durch klinische Updates eingeleitet, wovon im Folgenden das Referat zur Infektiologie resümiert wird. Frau Prof. Dr. med. Annelies Zinkernagel fokussiert ihre Ausführungen ausgehend von der kürzlich publizierten Liste der Top 10 Ursachen des Sterbens der WHO auf die Themen Impfungen (Neuer Impfplan 2019) und Antibiotika (warum und wie verschreiben und v.a. wie lang). Immerhin sind 6 der 10 Th emen infektiologischer Natur; die erwartete globale Influenza Pandemie, Antibiotika Resistenz, Ebola und andere hoch gefährliche Pathogene, Skepsis gegenüber Impfungen, Dengue und HIV. Sowohl Impfungen wie auch Antibiotikabehandlungen erwiesen sich im vergangenen Jahrhundert als hocheffiziente Massnahmen zur Senkung der Sterblichkeit an Infektionskrankheiten.
emen infektiologischer Natur; die erwartete globale Influenza Pandemie, Antibiotika Resistenz, Ebola und andere hoch gefährliche Pathogene, Skepsis gegenüber Impfungen, Dengue und HIV. Sowohl Impfungen wie auch Antibiotikabehandlungen erwiesen sich im vergangenen Jahrhundert als hocheffiziente Massnahmen zur Senkung der Sterblichkeit an Infektionskrankheiten.
Impfplan 2019
In Bezug auf den neuen Impfplan 2019 erläuterte die Referentin Punkte, welche in der Praxis im Umgang mit adulten Patienten von Bedeutung sind: Hepatitis B, Meningokokken, HPV, MMR und FSME. Seit der Einführung der Hepatitis-B-Impfung der Jugendlichen 1998 haben die Hepatitis-B-Fälle abgenommen, aber nicht bis Null. Wegen der nicht optimalen Impfakzeptanz der Jugendlichen wird im neuen Impfplan die Impfung der Säuglinge empfohlen zum Zeitpunkt 2, 4 und 12 Monate. Zusätzlich im Alter 11-15 Jahr und auch bei Erwachsenen > 16 Jahre bei bisher nicht geimpften.
Auch die Inzidenz von invasiven Meningokokken ist in der Schweiz in den letzten 10 Jahren zurückgegangen, insbesondere Infektionen der Gruppen B und C. Heute werden 82% der Infektionen verursacht durch Stämme der Gruppen C, W und Y. Dementsprechend wird seit Herbst 2018 empfohlen, den Impfstoff der Gruppe C zu ersetzen durch den quadrivalenten Impfstoff ACWY und damit immunsupprimierte Patienten, bei St. n. Splenektomie und Rekruten zu impfen mit Boost alle 5 Jahre, falls die Immunsuppression anhält.
HPV-Impfung: schlechte Akzeptanz trotz Krebsvorbeugung
Obwohl HPV Infektionen zu genitalen Warzen und Krebserkrankungen führen können, ist die Impfakzeptanz gering. Patienten entsprechend aufzuklären und zu motivieren hilft, Krebs zu verhindern, heute sollen alle Mädchen und Knaben zwischen 11 und 14 Jahre mit 2 Dosen geimpft werden, Intervall 6 Monate, ab 15 bis 25 Jahre 3 Dosen, Schema 0, 1 – 2, 6 Monate. Der 4-valente Impfstoff Gardasil® wird 2019 ersetzt durch die 9-valente Variante (Nachholimpfung nicht empfohlen). Der Grund, Personen bis zu 26 Jahre zu impfen, ist dadurch begründet, dass durchgemachte Infektionen nicht zuverlässig zu Serokonversionen führen und ungenügenden Schutz vor Neuinfektionen vermitteln. Im Gegensatz dazu führt die Impfung zu einer fast 100%-igen schützenden Serokonversion bei Mann und Frau, da natürliche Infektionen kaum Zugang zu Lymphknoten haben im Gegensatz zum intramuskulär verabreichten Impfstoff. Die Impfung im Alter von 11 bis 26 Jahren soll im Rahmen der kantonalen Impfprogramme erfolgen, die Kosten der Impfung werden dann übernommen.
Die Masernimpfung ist eine der grossen Erfolgsgeschichten der Medizin, seit der Einführung 1963 sind über 20 Millionen Todesfälle verhindert worden und die Inzidenz von Erkrankungen konnte seit Einführung der 2. Impfdosis in der Schweiz 1996 nochmals markant reduziert werden. Masern sind hoch kontagiös und wegen der heute weit verbreiteten Impfaversion muss weltweit eine Wiederzunahme von Erkrankungsfällen um 30% beobachtet werden. Es gilt, Impflücken zu schliessen bei allen ungenügend geimpften (weniger als 2 dokumentierte MMR Impfungen) Personen jünger als 1963. Die persönliche Empfehlung durch den Arzt spielt eine Schlüsselrolle bei der Motivation zu einer Nachholimpfung! Da heute de facto fast 50% der bis 3-jährigen, die sich bereits oft in Krippen, dem Tummelplatz der Masernviren, aufhalten, nicht geschützt sind, wurde der Impfplan angepasst und die neue Empfehlung lautet auf Impfung zum Zeitpunkt 9 und 12 Monate.
Zeckenencephalitis auf dem Vormarsch trotz wirk-samer und verträglicher Impfung
Arztbesuche wegen Zeckenstichen und Zecken-assoziierten Erkrankungen nehmen Jahr für Jahr zu. Insbesondere steigt die Zahl von an Zeckenenzephalitis FSME-Erkrankten ständig an und auch der Anteil an FSME IgM-Positivität steigt auf aktuelle 36% 2018. Auch hier existiert eine wirksame Impfung. Um Impflücken zu bekämpfen wurde die Impfempfehlung vom bisherigen Rat, Personen in FSME-Gebieten zu impfen neu auf alle Personen in der Schweiz mit Ausnahme von Genf und dem Tessin ausgeweitet (Abb. 1). Impfschema: 3 Dosen zu den Zeitpunkten 0, 1 und 6 Monate für FSME-Immun CC®; 0, 1 und 10 Monate für Encepur®. Auffrischimpfungen alle 10 Jahre empfohlen, die Notwendigkeit von häufigeren Auffrischimpfungen ist nicht belegt.
Wie lang sollen Antibiotika eingesetzt werden
Eine zentrale Frage beim Einsatz von Antibiotika betrifft die Dauer der Therapie. Neuere Arbeiten zeigen, dass deren Einsatz generell zu lange ist, was in der Angst vor Rückfällen begründet ist. Bei aktiven Infekten mit rascher Zellteilung der Erreger kann ein Antibiotikum Schlüsselmechanismen der Teilung hemmen und die Bakterien innert 3 bis 10 Tagen abtöten. Im Gegensatz dazu können sich schlafende Bakterien, Paradebeispiel Tuberkulose, der antibiotischen Wirkung entziehen. Neben der Lokalisation von Infekten in privilegierten Orten wie Abszess, intrazellulär oder Biofilm-assoziiert, wo die Antibiotika die Bakterien nicht erreichen und zur Behandlung oft operative Eingriffe notwendig werden, spielen bei chronischen Infekten sog. «Persisters», metabolisch inaktive Bakterien, eine wesentliche Rolle – sie benötigen eine langedauernde Therapie. Bei der Untersuchung von Bakterien aus sauren Milieus wie Abszesse oder von Biofilm finden sich oft schlecht wachsende Kolonien (Abbildung 2), die erst nach Wiederausstreichen zu wachsen beginnen und auch im Experiment kann gezeigt werden, dass gestresste Bakterien erst später zu wachsen beginnen und in dieser Phase Antibiotika z.T. extrem gut tolerieren. Der mikrobiologische Nachweis solcher Persisters kann folglich ein Indiz für die Notwendigkeit einer langen Therapiedauer sein kann. Bemerkenswerter Weise sind in der Schweiz genetische Resistenzen bei S.aureus selten, der Anteil an MRSA liegt bei unter 10%.
Quelle: VZI-Symposium, Zürich, 31. Januar 2019, Sitzung Update Infektiologie
Facharzt FMF Innere Medizin und Gastroenterologie
Neuhausstrasse 18
8044 Zürich
Schulthess_hk@swissonline.ch